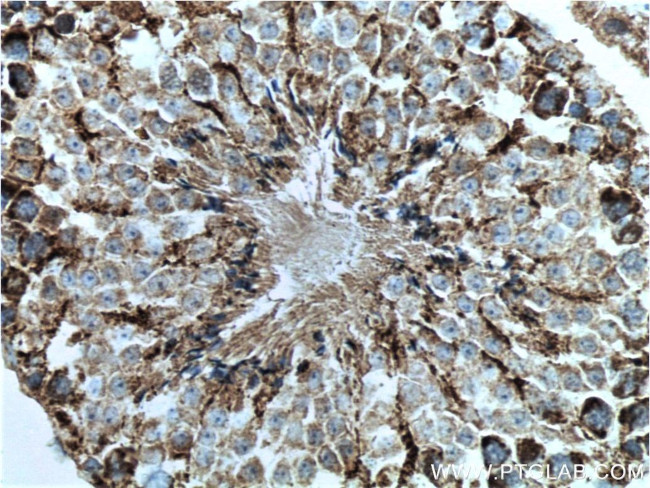
CHCHD4 Antibody in Immunohistochemistry (Paraffin) (IHC (P))

Search
Proteintech
CHCHD4 Polyclonal Antibody
{{$productOrderCtrl.translations['antibody.pdp.commerceCard.promotion.promotions']}}
{{$productOrderCtrl.translations['antibody.pdp.commerceCard.promotion.viewpromo']}}
{{$productOrderCtrl.translations['antibody.pdp.commerceCard.promotion.promocode']}}: {{promo.promoCode}} {{promo.promoTitle}} {{promo.promoDescription}}. {{$productOrderCtrl.translations['antibody.pdp.commerceCard.promotion.learnmore']}}
产品信息
21090-1-AP
种属反应
已发表种属
宿主/亚型
分类
类型
抗原
偶联物
形式
浓度
规格
纯化类型
保存液
内含物
保存条件
运输条件
产品详细信息
Immunogen sequence: MSYCRQEGK DRIIFVTKED HETPSSAELV ADDPNDPYEE HGLILPNGNI NWNCPCLGGM ASGPCGEQFK SAFSCFHYST EEIKGSDCVD QFRAMQECMQ KYPDLYPQED EDEEEEREKK PAEQAEETAP IEATATKEEE GSS (1-142 aa encoded by BC033775)
靶标信息
CHCHD4, a component of human mitochondria, belongs to a protein family whose members share 6 highly conserved cysteine residues constituting a -CXC-CX(9)C-CX(9)C- motif in the C terminus (Hofmann et al., 2005).
仅用于科研。不用于诊断过程。未经明确授权不得转售。
生物信息学
蛋白别名: Coiled-coil-helix-coiled-coil-helix domain-containing protein 4; Mitochondrial intermembrane space import and assembly protein 40; translocase of inner mitochondrial membrane 40 homolog; unnamed protein product
基因别名: 2410012P20Rik; 2810014D17Rik; AI838740; CHCHD4; MIA40; TIMM40
UniProt ID: (Human) Q8N4Q1, (Mouse) Q8VEA4, (Rat) Q5BJN5
Entrez Gene ID: (Human) 131474, (Mouse) 72170, (Rat) 312559